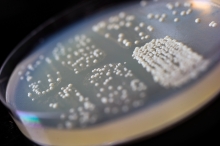
Budding yeast colonies2

The increasing acidification of ocean waters caused by rising atmospheric carbon dioxide levels could rob sharks of their ability to sense the smell of food, a new study suggests.

Dr. Marc Weissburg Professor of Biology, along with a team of multidisciplinary investigators have been awarded $2.5 million dollar grant to develop approaches for sustainable and resilient infrastructure

Researchers have sequenced the genomes and transcriptomes of five species of African cichlid fishes and uncovered a variety of features that enabled the fishes to thrive in new habitats and ecological niches within the Great Lakes of East Africa.
Scientists have shown that RNA from within cells of a common yeast can serve as a template for repairing DNA.
